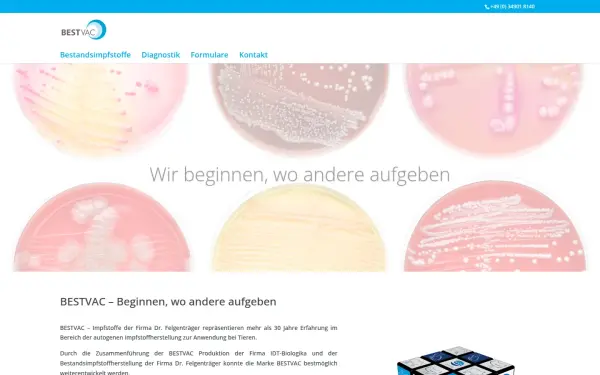

bestandsimpfstoffe.de
Bestandsimpfstoffe
Sprache: Deutsch
Charset: utf-8
Generator: Divi v.4.22.2
Robots-Anweisung: index, follow, max-snippet:-1, max-image-preview:large, max-video-preview:-1
Viewport: width=device-width, initial-scale=1.0, maximum-scale=1.0, user-scalable=0
Sicherheit und Einstufung
Die Website enthält laut CLOUDFLARE keine bedenklichen Inhalte und kann sowohl von Minderjährigen als auch in der Arbeit genutzt werden.
Rechtliches / Kontakt
Impressum:
https://bestandsimpfstoffe.de/impressum/
Kontakt:
https://bestandsimpfstoffe.de/
Der Betreiber dieser Domain befindet sich in 06861 Dessau
Sämtliche Sub-Domains der Haupt-Domain
bestandsimpfstoffe.de
bestandsimpfstoffe.de
Verwendete Technologien
-
Divi
Divi ist ein WordPress-Theme und ein eigenständiges WordPress-Plugin von Elegant Themes, mit dem Benutzer Websites mithilfe des visuellen Drag-and-Drop-Seitenerstellungsprogramms Divi erstellen können.
-
jQuery Migrate
Query Migrate ist eine Javascript-Bibliothek, die es Ihnen ermöglicht, die Kompatibilität Ihrer jQuery-Code für Versionen von jQuery älter als 1.9 entwickelt zu bewahren.
-
jQuery Mobile
jQuery Mobile ist ein HTML5-basiertes Benutzeroberflächensystem, das entwickelt wurde, um responsive Websites und Anwendungen zu erstellen, die auf allen Smartphone-, Tablet- und Desktop-Geräten zugänglich sind.
-
jQuery
jQuery ist eine JavaScript-Bibliothek, eine kostenlose Open-Source-Software, die das Traversieren und Manipulieren des HTML-DOM-Baums sowie die Ereignisbehandlung, CSS-Animation und Ajax vereinfacht.
-
MySQL
MySQL ist ein quelloffenes relationales Datenbankmanagementsystem.
-
Nginx
Nginx ist ein Webserver, der auch als Reverse Proxy, Load Balancer, Mail Proxy und HTTP Cache verwendet werden kann.
-
Open Graph
Open Graph ist ein Protokoll, das dazu dient, jede beliebige Webseite in den Social Graph zu integrieren.
-
PHP
PHP ist eine universelle Skriptsprache für die Webentwicklung.
-
Priority Hints
Priority Hints bietet Entwicklern einen Mechanismus, um Browsern eine relative Priorität zu signalisieren, die sie beim Abrufen von Ressourcen berücksichtigen können.
-
WordPress
WordPress ist ein kostenloses und quelloffenes Content-Management-System, das in PHP geschrieben und mit einer MySQL- oder MariaDB-Datenbank gekoppelt ist. Zu den Funktionen gehören eine Plugin-Architektur und ein Vorlagensystem.
-
WP Rocket
WP Rocket ist ein Caching- und Performance-Optimierungs-Plugin zur Verbesserung der Ladegeschwindigkeit von WordPress-Websites.
DNS-Einträge
IP-Adresse Server:
185.30.32.199